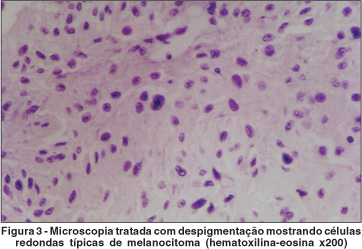

Arq. Bras. Oftalmol. 2004; 67 (2): 10.1590/S0004-27492004000200026
Total: 1884
Bernadete Ayres1; Hugo Soares Maia1; Sandra Molles2; Adriane Brazuna1
DOI: 10.1590/S0004-27492004000200026
RESUMO
Os autores relatam os achados clínicos e histopatológicos de um caso raro de melanocitoma de corpo ciliar. O paciente, do sexo masculino, 40 anos, apresentou extensa lesão pigmentada de corpo ciliar que foi diagnosticada como melanoma. Submetido a enucleação, o exame histopatológico revelou um raro melanocitoma de corpo ciliar, o qual apresenta características peculiares, devendo ser considerado com diagnóstico diferencial de lesões pigmentadas do segmento anterior.
Descritores: Neoplasias oculares; Melanoma; Corpo ciliar; Neoplasias uveais; Diagnóstico diferencial; Relato de caso
ABSTRACT
The authors report the clinical and histopathologic findings of a rare case of melanocytoma of the ciliary body. The pigmented ciliary body tumor was found in a 40-year-old man, with a clinical diagnosis of melanoma of the ciliary body. Histopathologic examination after enucleation showed typical features of melanocytoma. This case illustrates the pattern of ciliary body melanocytoma to help in the differential diagnosis of pigmented tumors of the ciliary body.
Keywords: Eye neoplasms; Melanoma; Ciliary body; Uveal neoplasms; Diagnosis, differential; Case report
Melanocitoma é um tumor intra-ocular benigno, densamente pigmentado e que comumente localiza-se ao nível do disco óptico ou adjacente a este, entretanto pode originar-se em qualquer região onde melanócitos ocorram. A ocorrência de melanocitoma de corpo ciliar é extremamente rara. Os autores descrevem um caso de melanocitoma de corpo ciliar.
RELATO DE CASO
Paciente masculino, 40 anos, branco, procurou atendimento com queixa de visão embaçada em olho esquerdo. O exame oftalmológico revelou acuidade visual sem correção 20/20 em OD e 20/30 em OE. A biomicroscopia do segmento anterior revelou em OE uma massa ao nível do corpo ciliar, estendendo-se de 9:30h a 1:00h, no sentido superior, de coloração castanho escura e superfície lisa (Figura 1). A pressão intra-ocular foi 14 mmHg em ambos olhos. Ao exame fundoscópico observou-se 2 nevus de coróide em OD e aspecto normal em OE. A ultra-sonografia (A e B scan) demostrou lesão sólida, cupuliforme, com estrutura interna regular e refletividade média, em corpo ciliar e periferia de coróide, superiormente, e espessura de 12,66 mm. O estudo ecográfico foi complementado com biomicroscopia ultra-sônica (freqüência de 50 MHZ), que demonstrou lesão sólida acometendo corpo ciliar e periferia coroidal superior, refletividade interna média, com áreas císticas e atenuação sonora. Avaliação sistêmica do paciente revelou-se normal. A hipótese diagnóstica foi de tumor melanocítico de corpo ciliar e periferia de coróide, provavelmente melanoma. Estadiamento sistêmico não revelou lesão metastática. Tratamento cirúrgico através de iridociclectomia não foi possível devido a grande extensão da lesão. Paciente foi submetido a enucleação do olho esquerdo.

O exame histopatológico da peça cirúrgica, revelou massa, densamente pigmentada, medindo 12 x 10 mm, localizada no corpo ciliar e coróide periférica (Figura 2). O exame histopatológico mostrou proliferação de células com grande concentrado de melanina. O material foi tratado para despigmentação e demonstrou células redondas, com citoplasma amplo e claro, com raras inclusões nucleares, nucléolos por vezes proeminentes, e ausência de figuras de mitose (Figura 3). Não foi observado infiltrado linfocitário. Os achados histopatológicos eram consistentes com melanocitoma de corpo ciliar.

DISCUSSÃO
O termo melanocitoma foi inicialmente introduzido por Zimmerman e Garron(1) descrevendo tumor benigno pigmentado do disco óptico, constituído por grandes células, uniformes, poliédricas, densamente pigmentadas. Cogan(2) propôs o termo nevus magnocelular, caracterizando a natureza benigna da lesão. Melanocitoma freqüentemente localiza-se no disco óptico ou adjacente a este, raramente apresenta localização extrapapilar, como íris(3), coróide(4), esclera(5), conjuntiva(6) e corpo ciliar(7-12). Em uma revisão de peças anatomopatológicas de 907 tumores pigmentados, Howard e Forrest(13) encontraram somente 5 casos de melanocitoma, e dois destes localizavam-se no corpo ciliar.
Melanocitoma de corpo ciliar apresenta alguns achados típicos. Ocorre geralmente em adultos, com a média de idade de 48 anos por ocasião do diagnóstico. Existe uma predisposição racial, acometendo principalmente a raça branca(7,14), contrário ao melanocitoma de disco óptico, o qual acomete a raça negra com maior freqüência. O acometimento freqüentemente é unilateral e a visão mantém-se preservada.
Clinicamente, o melanocitoma de corpo ciliar, apresenta coloração variando de castanho escuro a negro. Pode ocorrer extensão para raiz da íris, trabeculado, esclera e episclera(7,10-11,14). Pode haver glaucoma secundário, causado pela invasão do canal de Schlemm, seja por dispersão de melanina ou por extensão direta do tumor(12). O controle da pressão intra-ocular é difícil e as cirurgias filtrantes podem levar a disseminação de células tumorais.
Juarez e Tso(15) através de estudos com microscopia eletrônica, identificaram dois tipos celulares de melanocitoma. No tipo 1, as células são poliédricas, apresentam melanossomos gigantes e poucas organelas citoplasmáticas. No tipo 2, as células são pequenas, fusiformes, contém nucléolos proeminentes, numerosas mitocôndrias, ribossomos e retículo endoplasmático rugoso, pressupondo alto grau de atividade metabólica, provavelmente relacionado com o potencial de crescimento do tumor.
Existem relatos de malignização em casos de melanocitomas(8,16-17). Heitman(8) observou um caso de melanoma, envolvendo corpo ciliar e coróide, que continha focos de células anaplásticas em meio a células poliédricas, estas típicas de melanocitoma.
O diagnóstico clínico de melanocitoma é extremamente intricado devido sua rara ocorrência. A principal característica do tumor é sua densa pigmentação e superfície lisa. A ultra-sonografia é extremamente valiosa auxiliando o diagnóstico, revelando lesão sólida, cupuliforme, estrutura interna regular com refletividade alta, quando localizado no disco óptico(18-19), entretanto quando localizado no corpo ciliar apresenta refletividade interna média(7,11).
O principal diagnóstico diferencial em pacientes suspeitos de melanocitoma de corpo ciliar é o melanoma. Ambos os tumores podem apresentar grandes dimensões e densa pigmentação, tornando o diagnóstico clínico dificultoso. De acordo com o tamanho, lesões pigmentadas com espessura maior que 2,0 mm são fortemente sugestivas de melanoma(20). O presente caso apresenta espessura de 12,66 mm, pouco provável de tratar-se de neoplasia benigna, altamente sugestivo de neoplasia maligna pelo seu grande tamanho.
Entre as lesões do corpo ciliar, o diagnóstico diferencial também inclui: hiperplasia do epitélio pigmentar, meduloepitelioma, adenoma e adenocarcinoma. A hiperplasia de epitélio pigmentar ocorre após trauma ocular, processo inflamatório ou intervenção cirúrgica. Meduloepitelioma é uma neoplasia maligna típica da infância, apresenta coloração que varia do cinza ao róseo e ecograficamente possui cisto em sua estrutura interna. Adenoma e adenocarcinoma originam-se do epitélio não pigmentar, são claros e possuem superfícies irregulares(21).
Em relação ao tratamento, a iridociclectomia é indicada para tumores envolvendo menos que 3 meridianos horários(22). A ressecção de lesões maiores que 3 meridianos possivelmente acarretarão complicações que inviabilizarão visão útil.
O presente caso ilustra a ocorrência rara de melanocitoma de corpo ciliar. O diagnóstico de melanocitoma de corpo ciliar constituí um grande desafio. A natureza pigmentada e a grande dimensão do tumor podem mimetizar lesão maligna, entretanto não afastam o melanocitoma do diagnóstico diferencial de melanoma. Os achados do presente caso confirmam a raridade da patologia e a dificuldade em estabelecer o diagnóstico.
REFERÊNCIAS
1. Zimmerman LE, Garron LK. Melanocytoma of the optic disc. Int Ophthalmol Clin 1962;2:431-40.
2. Cogan DG. Discussion pigmented ocular tumors. In: Boniuk M, editor. Ocular and adnexal tumors. St Louis: CV Mosby; 1964. p.385.
3. Shields JA, Annesley Jr WJ, Spaeth GL. Necrotic melanocytoma of the iris with secondary glaucoma. Am J Ophthalmol 1977;84:826-9.
4. Shields JA, Font RL. Melanocytoma of the choroid clinically simulating a malignant melanoma. Arch Ophthalmol 1972;87:396-400.
5. Lee JS, Smith RE, Minckler DS. Scleral melanocytoma. Ophthalmology 1982;89:178-82.
6. Verdaguer J, Valenzuela H, Strozzi L. Melanocytoma of the conjunctiva. Arch Ophthalmol 1974;91:363-6.
7. Frangieh GT, el Baba F, Traboulsi EI, Green WR. Melanocytoma of the ciliary body: presentation of four cases and review of nineteen reports. Surv Ophthalmol 1985;29:328-34.
8. Heitman KF, Kincaid MC, Steahly L. Diffuse malignant change in a ciliochoroidal melanocytoma in a patient of mixed racial background. Retina 1988;8: 67-72.
9. Char DH, Miller TR, Crawford JB. Cytopathologic diagnosis of benign lesions simulating choroidal melanomas. Am J Ophthalmol 1991;112:70-5.
10. Stokes DW, O'Day DM, Glick AD. Melanocytoma of the ciliary body with scleral extension. Ophthalmic Surg 1993;24:200-2.
11. Rummelt V, Naumann GOH, Folberg R, Weingeist TA. Surgical management of melanocytoma of the ciliary body with extrascleral extension [commented on Am J Ophthalmol 1994;118:404-5]. Am J Ophthalmol 1994; 117:169-76.
12. Biswas J, D'Souza C, Shanmugam MP. Diffuse melanotic lesion of the iris as a presenting feature of ciliary body melanocytoma: report of a case and review of the literature. Surv Ophthalmol 1998;42:378-82.
13. Howard GM, Forrest AW. Incidence and location of melanocytomas. Arch Ophthamol 1967;77:61-6.
14. LoRusso FJ, Boniuk M, Font RL. Melanocytoma (magnocellular nevus) of the ciliary body: report of 10 cases and review of the literautre. Ophthalmology 2000;107:795-800.
15. Juarez CP, Tso MO. An ultrastructural study of melanocytoma (magnocellular nevi) of the optic disc and uvea. Am J Ophthalmol 1980;90:48-62.
16. Barker-Griffith AE, Green WR, McDonald PT. Malignant melanoma in a choroidal magnocellular nevus (melanocytoma). Can J Ophthalmol 1976;1:140-6.
17. Roth AM. Malignant changes in melanocytoma of the uveal tract. Surv Ophthalmol 1978;22:402-12.
18. Di Bernardo C, Schachat AP, Fekrat S. Intraocular tumors. In: Di Bernardo C, Schachat AP, Fekrat S. Ophthalmic ultrasound: a diagnostic atlas. New York: Thieme, 1998. p.87-107
19. Byrne SF, Green RL Intraocular tumors. In: Byrne SF, Green RL. Ultrasound of the eye and orbit. St. Louis: Mosby Yearbook; 1992. p.180-1
20. Naumann G, Yanoff M, Zimmerman LE. Histogenesis of malignant melanoma of the uvea. I. Histopathologic characteristics of nevi of the choroid and ciliary body. Arch Ophthalmol 1966;76:784-96.
21. Shields JA, Eagle Jr RC, Shields CL, De Potter P. Acquired neoplasms of the nonpigmented ciliary epithelium (adenoma and adenocarcinoma). Ophthalmology 1996;103:2007-16.
22. Raichand M, Peyman GA, Juarez CP, Seetner AA, Sugar J, Goldberg MF. Resection of uveal melanocytoma: clinicopathological correlation. Br J Ophthalmol 1983;67:236-43.
Endereço para correspondência
Bernadete Ayres
Avenida Oswaldo Cruz, 135, apto 901
Rio de Janeiro (RJ) CEP 22250-060
E-mail: [email protected]
Recebido para publicação em 23.01.2003
Versão revisada recebida em 08.08.2003
Aprovação em 02.12.2003
How to cite this article: